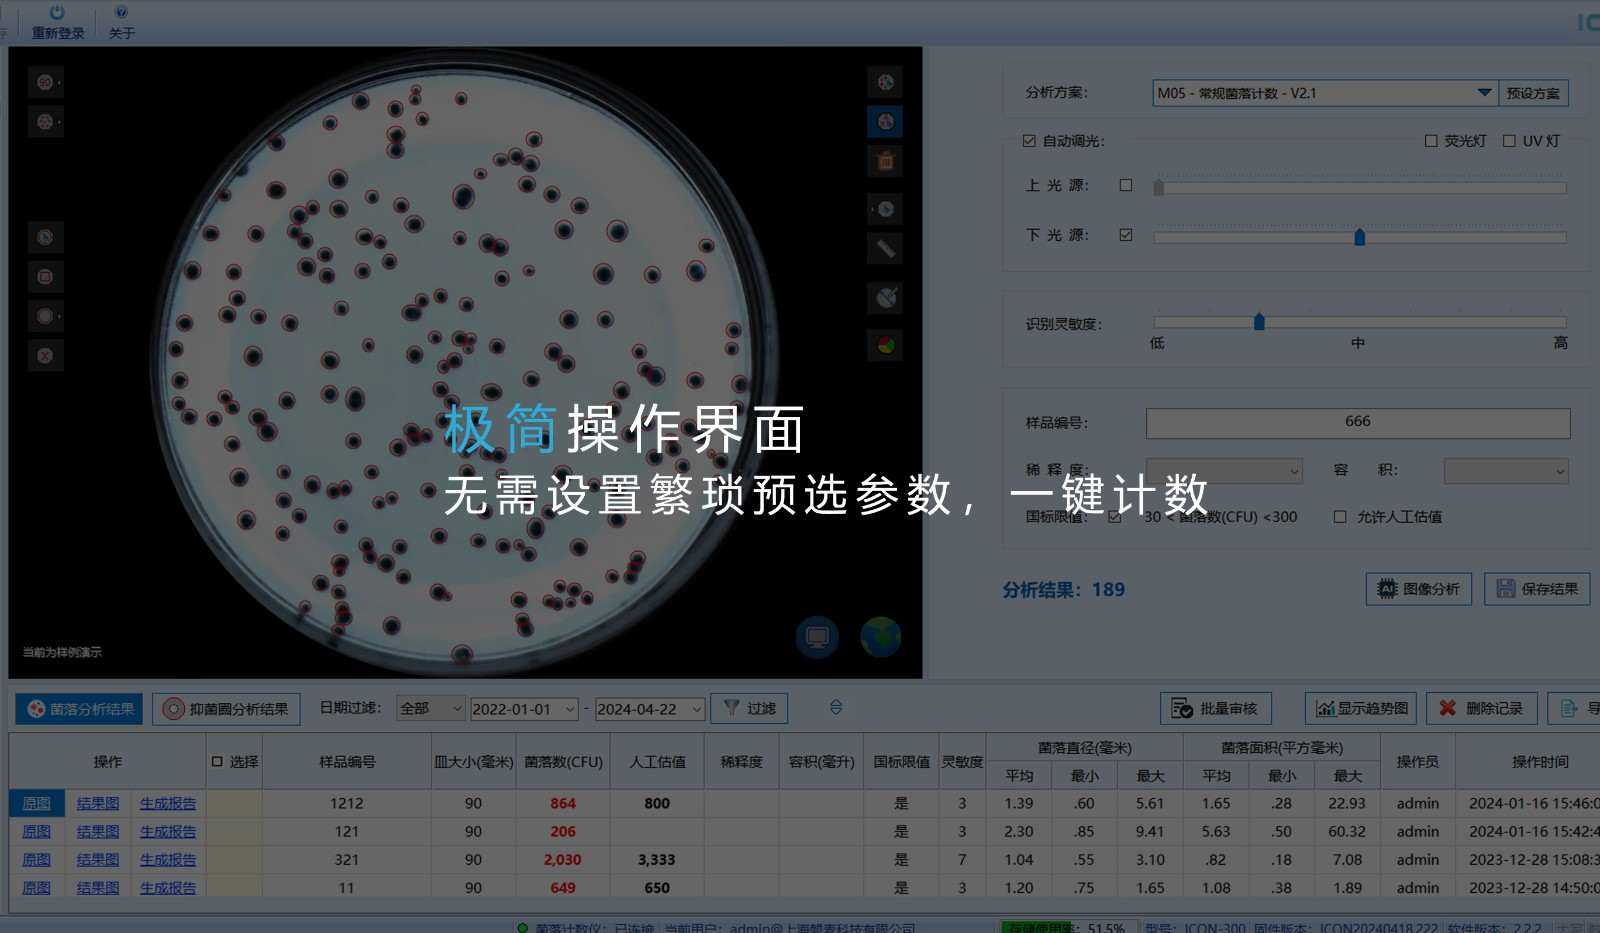
ICON 自动菌落计数仪规格图

自动菌落计数仪
 新品
新品
产品描述
ICON自动菌落计数仪,独创AI智能算法计数,自主学习不易识别菌落形态,完善菌落库,计数识别准确率高达98%,极其简易的操作界面,让用户只需简单点击按键即可完成菌落计数。
极简操作设置
极简化软件设置界面,无需手动设置机械开关和繁杂的预选参数,一键分析,最快3秒计数
独创AI智能算法
AI算法主动对陌生形态菌落进行学习和训练,菌落计数更快更准,计数准确率>98%
全面自动化扩展
开放应用程序编程接口(API)可任意联接外源机械手
产品规格
运算系统:嵌入式运算系统,运算核心内置于主机中,避免电脑病毒等异常因素引起的损坏
软件系统:人工修正支持区域选择、区域反选、单个增加、单个删除,支持预选多区域同时计数分析
计数类型:支持螺旋涂布法、倾注法、纸片法、膜片过滤法、接触碟计数、手套压印计数等
菌落识别:具有杂质区分能力、气泡区分能力、粘连菌落区分能力、异形菌落区分能力、菌落重叠区分能力
样品规格:60mm/90mm/120mm/150mm标准圆形培养皿,系统自动识别
灯源:内置顶光源、底光源,无需机械开关控制,自动调光,254nm紫外灯用于样品仓消毒(可选),366nm紫外灯用于荧光法菌落计数(可选)
样品仓:全暗样品仓,电动仓门
数据传输:千兆网线或WIFI无线数据传输

产品特点
自主学习不易识别菌落形态,完善菌落库
版权所有 © 上海谱艾达科学仪器有限公司

 13917986725
13917986725